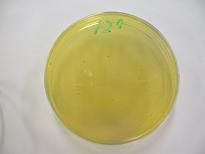
培養後のBCPﾌﾟﾚｰﾄｶｳﾝﾄ寒天培地

身近な菌を見てみよう!~ヨーグルト~
ヨーグルトの中の菌を見てみよう!
ヨーグルト(はっ酵乳)は,国の基準で乳酸菌が1ml 当たり1千万個以上
含まれていることが決められています。
試験検査課では,定期的にヨーグルトの検査をして,
乳酸菌数が規定量以上入っているかどうか調べています。
ヨーグルトの中には,どんな菌がいるのか見てみましょう。
ヨーグルトを,培地(栄養分と色素が入った寒天)に加えて培養すると,
培地の色は紫色(写真1)から黄色(写真2)に変化し,黄色い点々(写真3)が見えてきました。
写真1 写真2

この黄色い点々をコロニーと呼んでいます。(写真3)
コロニーは,1つの菌が目に見えるまで増えたものです。
1つ1つのコロニーを数えて,1ml 中の乳酸菌数を計測します。
コロニーから菌を採って,紫色の色素で染め,顕微鏡で1000倍に拡大すると,
楕円形の菌が集まって見えました。(写真4)
写真3 写真4


検査したヨーグルトの乳酸菌は,1g 中に3億3000万個でした。
このヨーグルトは85g入りなので,1個食べると約280億個の乳酸菌を食べることになるのですね!